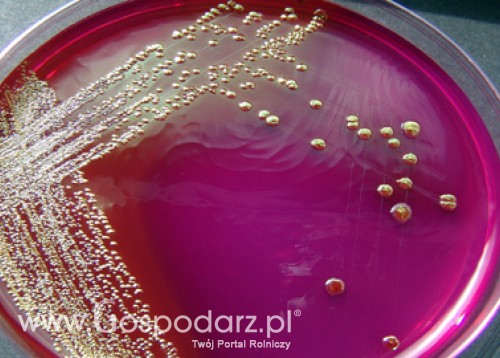
Zasady prowadzenia w Polsce monitoringu na obecność Shiga toksycznych bakterii E. coli

Logowanie
Losowe firmy
Wiadomości
Kurs walut
| 1 USD | 3,0938 | |
| 1 EUR | 4,1858 | |
| 1 GBP | 4,8732 | |
| 1 CHF | 3,3629 | |
| Kursy średnie NBP | ||
| Notowanie z dnia: 2013-01-30 | ||
Wydarzenia
 wstecz
wstecz |
styczeń 2026 | dalej |
| Pn. | Wt. | Śr. | Cz. | Pt. | Sb. | Nd. |
|
|
|
|
01 |
02 |
03 |
04 |
|
05 |
06 |
07 |
08 |
09 |
10 |
11 |
|
12 |
13 |
14 |
15 |
16 |
17 |
18 |
|
19 |
20 |
21 |
22 |
23 |
24 |
25 |
|
26 |
27 |
28 |
29 |
30 |
31 |
|

Losowe tagi
Najbliższe imprezy
Zasady prowadzenia w Polsce monitoringu na obecność Shiga toksycznych bakterii E. coli
Dodane 2011-07-20, Kategoria: Państwowa Inspekcja Ochrony Roślin i Nasiennictwa, Komentarzy: 0
W dniu 20 lipca br. Federacja Rosyjska przywraca możliwość importu z Polski warzyw świeżych wyprodukowanych w Polsce.
czytaj więcej
czytaj więcej
Główny Inspektorat Ochrony Roślin i Nasiennictwa w sprawie eksportu warzyw do Federacji Rosyjskiej
Komentarzy:
0
2011-07-07
czytaj więcej
czytaj więcej
Komentarzy:
0
2011-06-06
czytaj więcej
Komunikat Głównego Inspektora Ochrony Roślin i Nasiennictwa dotyczący polskich upraw warzyw
Komentarzy:
0
2011-05-31
czytaj więcej
czytaj więcej
czytaj więcej
Komunikat Główne Inspektoratu Ochrony Roślin i Nasiennictwa w sprawie środków ochrony roślin
Komentarzy:
0
2011-04-19
czytaj więcej
czytaj więcej
czytaj więcej
Komunikat Głównego Inspektoratu Ochrony Roślin i Nasiennictwa w sprawie systemu jakości żywności
Komentarzy:
0
2011-03-09
czytaj więcej
Komunikat Głównego Inspektoratu Ochrony Roślin i Nasiennictwa w sprawie certyfikatów bezpieczeństwa
Komentarzy:
0
2011-03-01
Komentarzy:
0
2011-01-31
czytaj więcej
czytaj więcej
czytaj więcej
Spotkanie Głównego Inspektora Ochrony Roślin i Nasiennictwa z eksporterami i producentami
Komentarzy:
0
2011-01-05
czytaj więcej
czytaj więcej
czytaj więcej
Wiadomości giełdowe
Uspokojenie na światowym rynku zbóż (30.01.2013)
Wtorek był kolejnym spokojnym dniem na giełdowym rynku zbóż. Brakuje wyraźnych impulsów do dalszych wzrostów zapoczątkowanych po raporcie USDA z 11 stycznia. Światowy bilans zbóż zwłaszcza paszowych ma szansę się poprawić pod warunkiem, że susza utrzymująca się od kilku tygodni na kluczowych obszarach w Ameryce Południowej nie wyrządzi znaczących szkód. czytaj więcej
Losowo wybrane produkty
Produkcja roślinna
Biznes
Finanse
Ambitne cele prezydencji Irlandii w zakresie reformy Wspólnej Polityki Rolnej
Od 2013 roku w Polsce zwiększył się zakres kontroli tzw. wymogów wzajemnej zgodności w gospodarstwach rolnych (cross compliance - obszar C)
W 2012 roku rynek w branży leasingowej zwolnił. Wyraźny wzrost leasingu maszyn rolniczych i maszyn dla przemysłu spożywczego
ELF - aplikacja do wypełniania i drukowania wniosku o dopłaty do materiału siewnego [pobieralnia]
Ostatnio dodane galerie

Osłony dla roślin
Dodał: fioreo komentarzy: 4, suma ocen: +2 wyświetleń: 354
wyświetleń: 354
Kwiaty polskich producentów
Dodał: fioreo komentarzy: 0, suma ocen: +1 wyświetleń: 333
wyświetleń: 333
Polskie Róże
Dodał: fioreo komentarzy: 1, suma ocen: +2 wyświetleń: 360
wyświetleń: 360
Marolex Sp. z o.o. na targach Agro Show 2012r.
Dodał: marolex komentarzy: 0, suma ocen: +0 wyświetleń: 467
wyświetleń: 467
GiANT 4548 Tendo HD Ładowarka teleskopowa
Dodał: Chemirol komentarzy: 1, suma ocen: +1 wyświetleń: 397
wyświetleń: 397

Najnowsze posty na forum
-
Nowy wygląd Portalu Gospodarz.pl
dodał: mikolaj -
Szokujące wyniki badań dotyczących długotrwałego spożywania roślin GMO [video]
dodał: mikolaj -
Nowy system wywozu śmieci. Wasze opinie
dodał: minister_kopek -
Opinia o John Deere
dodał: endi13 -
"I wiesz co jesz" - uwagi, opinie, sugestie
dodał: mikolaj -
Ile zapłacimy za wywóz śmieci? Akcja Gospodarz.pl
dodał: Jaskier -
Las z podniebnej perspektywy - niesamowite zdjęcia, które musisz zobaczyć
dodał: Jaskier -
Skup bydła Włodzimierz Kryszak Ciążeń
dodał: mirek65 -
Ceny choinek w 2012 roku
dodał: mikolaj -
Wstawianie filmów z YouTube na Forum Gospodarz.pl
dodał: mikolaj









 Wzór rocznego planu łowieckiego – wersja DOC
Wzór rocznego planu łowieckiego – wersja DOC Największa halowa wystawa maszyn w Polsce - Polagra...
Największa halowa wystawa maszyn w Polsce - Polagra...



































































